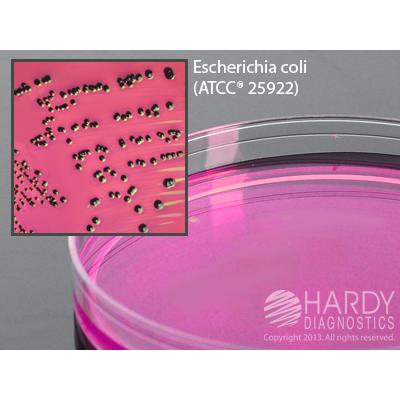

m Endo LES Agar, 15x100mm plate, Hardy Diagnostics
$33
Image | SKU | Description | Quantity | Price | Add to Cart |
---|---|---|---|---|---|
![]() |
G28 | m Endo LES Agar, 15x100mm plate | 10 Pack | $33 |
Description
For the enumeration of coliforms from water specimens by membrane filter technique.
Features and Benefits
- Optically clear polystyrene
- For distortion free viewing.
- Heavy-Duty
- Reduces breakage during shipping.
- Stacking rings
- Polystyrene Petri plates feature raised rings for stacking ability and prevents sliding.
- Breathable Packaging
- Packaged in sleeves of 10 plates in a "breathable" bag that prevents buildup of condensation and excess moisture.
This media is to be stored and incubated in the dark. If you have a light in your refrigerator, incubator, or you leave the media exposed to light on the bench top, Hardy Diagnostics offers free Blok-Boxes. Blok-Box is a reusable cardboard box that hold one PK10 of media plates.